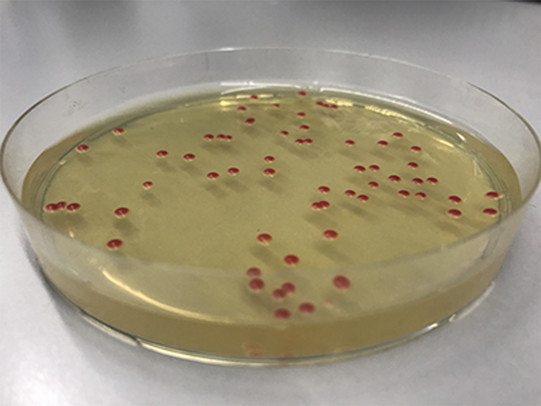
Knospende Hefen Knospende Hefen

Research
Genome Integrity
A stable genome is a fundamental requirement of life. Therefore, all eukaryotes have an elaborate network of maintenance mechanisms that ensure genome integrity. Broadly, we can subdivide these mechanisms into those that ensure accurate copying of the genetic information through DNA replication and those that deal with DNA damage, repair these damages and restore genome integrity. Occasionally, these genome integrity mechanisms falter, thereby driving ageing and giving rise to the occurrence of cancer. We therefore aim to understand how genome integrity is controlled and how this control is subverted in ageing and cancer.
Our Research
I. DNA damage
Breaks in the DNA (DNA double strand breaks, DSBs) are a key threat to genome stability. Eukaryotes have evolved several mechanisms to repair DSBs. The cellular decision-making process how to repair a specific DSB is still poorly understood, but recent research suggests that the DSB-surrounding chromatin plays a key role. We use approaches from cell biology, genetics as well as protein biochemistry, to study how DSB repair is influenced by cell and chromatin states. In particular, they utilize and develop next-generation sequencing (NGS) workflows to quantify DSB repair on the level of cell populations and single cells.
DSB repair is also of critical importance for genome editing, where DSBs can be induced by CRISPR-Cas9 or related tools, but the outcome of the genome editing reaction is often heterogeneous due to the endogenous DSB repair decisions. Therefore, we aim to translate knowledge of DSB repair into synthetic tools to exogenously control the DSB repair decision and to thereby determine the outcome of genome editing reactions.
The importance of DSB repair and the DSB repair decision is highlighted by the frequency that mutations in key DSB repair genes (such as the BRCA genes) are found to drive cancer formation. Importantly, these deficiencies can also be exploited in cancer therapy. The team therefore develops methods to visualize and quantify DSBs and other forms of DNA damage.

II. DNA replication
Whenever cells duplicate, they need to precisely copy and inherit their genome. Every stretch of DNA has to be replicated precisely once and accordingly the initiation of DNA replication has to be tightly controlled by a so-called ‘single-shot’ mechanism. Deregulation of this control leads to replication stress and genomic instability - the cause of cancer.
Our lab aims to understand DNA replication control and how subversion of this control leads to replication stress. We use the yeast Saccharomyces cerevisiae as a model system, which offers the advantage of using elegant genetic tools in combination with quantitative biochemical methods and modern genomic and proteomic approaches. Importantly, using Saccharomyces cerevisiae we have generated genetic systems that allow to deregulate DNA replication and study how subversion of replication control leads to replication stress and loss of genome integrity.
Our successes:
Our team has identified several cellular mechanisms that control DNA repair and DNA replication. By synthetically manipulating these controls we could furthermore generate new model systems for the study of genome integrity. Since defects in genome integrity are a defining hallmark of cancer, insights into the basic mechanisms of DNA repair and DNA replication will be of key importance for the discovery of new cancer markers, as well as therapeutic intervention.
Our goals:
Our team aims to develop NGS-based methods to identify and localize DNA damages and to follow their repair. Moreover, they aim to identify currently unknown controls of the DSB repair decision and utilize this knowledge for improving genome editing methodology. Lastly, a long-term goal of the group is to understand how changes in the genome maintenance network that occur during ageing drive cancer formation and other ageing-associated pathologies.
Our methods/techniques:
The Pfander group combine studies in yeast and human cancer cells. We apply Omics methods as well as classic genetic and cell biology approaches. In particular, in order to reveal the action of DNA repair enzymes, we use and develop next-generation sequencing approaches and workflows.